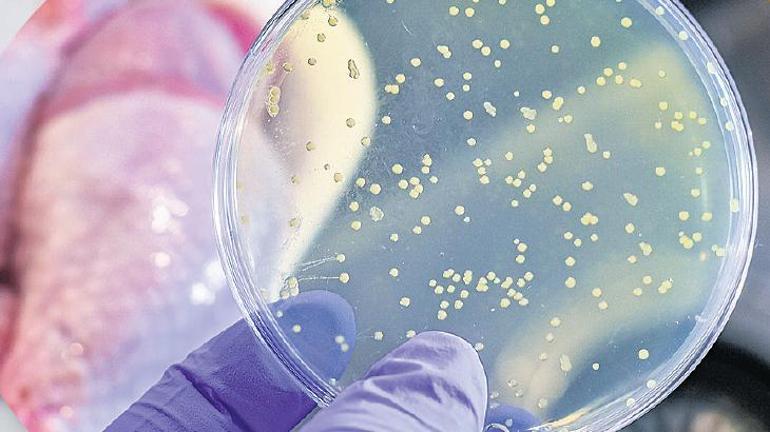

Görünmez tehlike aslında çok yakın
Her gün tükettiğiniz yiyecekler, doğru saklama, pişirme koşullarından biraz uzaklaşıldığında ciddi sağlık sorunlarına neden olabiliyor. Evde hazırlanan yemeklerde bile basit bir hijyen ihlali gıda zehirlenmesine yol açabilir
Son günlerde yaşanan acı olaylar, gıda güvenliğinin ne kadar hayati bir konu olduğunu hepimize yeniden hatırlattı. Gıda zehirlenmesiyle ilgili art arda medyaya yansıyan haberler, bu görünmez tehlikenin aslında ne kadar yakın olduğunu gösteriyor. Gıda güvenliği, sadece hijyen değil; içerik şeffaflığı, denetim, izlenebilirlik ve tüketici bilinçlenmesi demektir. Gıda zehirlenmeleri kimi zaman hafif mide bulantılarıyla ve sindirim sorunlarıyla atlatılsa da bazı durumlarda maalesef kalıcı hasarlara hatta ölümcül sonuçlara neden olabilir.
Salmonella, E. coli, listeria ve campylobacter gibi bakteriler, yanlış saklanmış ya da iyi pişirilmemiş gıdalarda hızla çoğalabilir. Bazen tat ve koku tamamen normal görünse bile yiyecekler tehlikeli miktarda patojen içerebilir. Belirtiler genellikle birkaç saat ile birkaç gün içinde ortaya çıkar. Bulantı, kusma, ishal, ateş, karın ağrısı ve halsizlik en sık görülen semptomlara örnek verilebilir. Ancak bağışıklık sistemi zayıf bireylerde, bebeklerde, yaşlılarda veya gebelerde tablo çok daha ağır seyredebilir. Özellikle listeria gibi bakteriler, hamileler için hayati tehlike oluşturabilecek kadar güçlüdür.
Neden artışta?
Gıda zehirlenmelerinin temelinde çoğu zaman günlük yaşamda yapılan basit hatalar yatar. Bozulmuş gıdaların fark edilmemesi, yiyeceklerin yeterince pişirilmemesi, çiğ ve pişmiş gıdaların aynı ekipmanla hazırlanması, gıdaların uygun sıcaklıklarda saklanmaması ve toplu yemek üretiminde hijyen eksiklikleri en yaygın sorunlar arasındadır. Özellikle hayvansal gıdalar; tavuk, kırmızı et, deniz ürünleri yüksek risk taşıyan gruba örnek verilebilir. Bu ürünlerin hem hazırlık hem de pişirme aşamalarında hijyen kurallarına dikkat edilmediğinde tehlike kaçınılmaz hâle gelir. Son zamanlarda yaşanan olaylar, toplu yemek üreten yerlerdeki küçük hijyen hatalarının bile ne kadar büyük sonuçlar doğurabileceğini gösteriyor. Bu nedenle denetimlerin sıkılaştırılması kadar tüketicilerin de bilinç seviyesinin yükseltilmesi kıymetli.

Nelere dikkat etmeli?
Gıda güvenliği, hem ev mutfaklarında hem de profesyonel mutfaklarda üzerinde titizlikle durulması gereken bir konu. Soğuk zincirin korunması, çiğ ve pişmiş gıdaların ayrı alanlarda hazırlanması, kesme tahtaları ve bıçakların ayrılması, buzdolabı sıcaklığının düzenli olarak kontrol edilmesi ve yiyeceklerin uygun sürelerde saklanması temel adımlar arasında. Aynı şekilde yiyecek çözdürme işlemlerinin tezgâh üzerinde değil, buzdolabı koşullarında yapılması, dışarıdan alınan hazır yemeklerde tazelik, temizlik ve güvenilirlik gibi kriterlere dikkat edilmesi gerekiyor. Dondurulmuş ürünleri çözülmeden buzluğa kaldırmalı, süt ürünleri, çiğ et ve balığı mutlaka 0-4°C arasında saklayarak kısa sürede tüketmelisiniz. Bir kez çözünen ürünü yeniden dondurmamak da kritik bir kuraldır. Sebze ve meyveleri tüketmeden önce bol suyla yıkamak, yiyeceklerin yeterli sıcaklıkta iyice piştiğinden emin olmak zararlı bakterilerin riskini azaltır. Evde hazırlanan yemeklerde bile basit bir hijyen ihlali gıda zehirlenmesine yol açabilir. Bu nedenle ellerinizi en az 20 saniye yıkamaya, yiyeceklerin iyi pişirilmesine, son kullanma tarihi geçen ürünleri tüketmemeye özen gösterin.
Zehirlenme şüphesinde ne yapılmalı?
Gıda zehirlenmesi şüphesi durumunda bol sıvı tüketmek, dinlenmek ve ağır yiyeceklerden kaçınmak ilk adımlardır. Ancak şiddetli kusma, kanlı ishal, yüksek ateş, bilinç bulanıklığı gibi belirtiler ortaya çıkarsa vakit kaybetmeden sağlık kuruluşuna başvurulmalıdır. Bebekler, yaşlılar, hamileler ve kronik hastalığı olan bireylerde belirtiler hafif bile olsa profesyonel değerlendirme gereklidir.
Yemekhanelerden restoranlara
Gıda zehirlenmesi sadece bireysel bir sorun değildir, geniş çaplı etkiler yaratabilir. Okul yemekhaneleri, hastane mutfakları, catering firmaları, restoranlar ve sokak satıcıları gıda güvenliği konusunda büyük sorumluluk taşır. Denetimlerin sıklaştırılması kadar, bu işletmelerde çalışan personelin eğitimi ve tüketicilerin bilinçlendirilmesi de en az o kadar önemlidir.
Sofradaki gıda yük olmasın
Son günlerde okuduğum bir kitaptan da örnek vermek istiyorum. Theresa MacPhail’in “Alerjik” adlı kitabında vurguladığı gibi bağışıklık sistemimiz artık sadece mikroplara değil, modern dünyanın yarattığı yeni tehditlere de tepki veriyor. Kitapta neden alerjimiz olduğunu, alerjilerin tüm dünyada giderek ağırlaşmasının nedenlerini, bunun hızla değişen dünyada insanlığın kaderi açısından ne anlama gelebileceğini anlatılıyor. Ama ben bunu farklı bir bakış açısıyla değerlendireceğim. Gıdaların üretim, işleme ve depolama koşulları değiştikçe bağışıklık sistemi de buna uyum sağlamaya çalışıyor. Özellikle hijyen eksiklikleri, bozulmuş gıdalar, çapraz bulaşma ve çevresel toksinlerin bağışıklık sistemimizi sürekli tetiklediğini ve bu yükün alerjilerden otoimmün hastalıklara kadar geniş bir yelpazede etkiler yaratabileceğini hatırlatmakta fayda var. Bu bakış açısı, gıda güvenliğinin aslında sadece ‘zehirlenme riskini’ azaltmakla sınırlı olmadığını, bağışıklık sistemini korumak için de kritik bir ihtiyaç olduğunu gösteriyor. Yani soframıza koyduğumuz her gıda, bağışıklık sistemimize ya destek oluyor ya da yük bindiriyor.
Sende Yorum yap